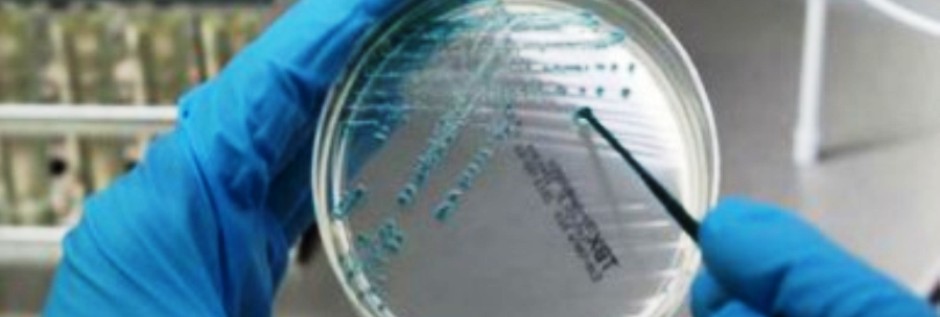

Scatta la paura Legionella a Palermo dopo che un noto albergo è stato chiuso così come uno stabile interdetto dopo la scoperta del batterio della Legionella.
Cosa è e cosa causa la Legionella
Si tratta di un batterio che si sviluppa, di solito, nelle acque stagnanti ma può annidarsi anche nelle tubature. Se ingerito po, in taluni casi, anche solo inalato, causa mal di testa, nausea e un malessere generale che porta velocemente alla febbre anche alta. In alcuni casi può presentare anche sintomi neurologici anche se transitori.
I controlli nelle tubature del centro di Palermo
Dopo le prime scoperta sono scattati i controlli a tappeto in tutta la zona del centro di Palermo ad iniziare dall’area del Politeama “Tutti i campionamenti eseguiti a Palermo nelle condutture dell’acqua fino al contatore ad oggi hanno dato esito negativo. La presenza della legionella che supera il livello consentito dipende dagli impianti degli edifici e delle strutture alberghiere interessati dal fenomeno” affermano dall’Asp di Palermo. I tecnici in questi giorni stanno eseguendo controlli e campionamenti in diversi edifici del centro e in svariate strutture di accoglienza della medesima area.
Dieci giorni per l’esito dai campioni prelevati
“Per avere gli esiti sugli esami servono almeno dieci giorni – aggiungono però dall’azienda sanitaria palermitana – Tanto è necessario per stabilire con certezza se quell’impianto è sicuro oppure conoscere il livello della legionella eventualmente presente” Il batterio della Legionella, infatti, ricordano dall’Asp “sempre presente ma deve restare entro precisi limiti di legge”. Dunque le campionature servono a verificare i casi un cui il batterei “supera il limite consentito dalle normative vigenti”.
Il ceppo che ha causato problemi
Il batterio che causa un’infezione polmonare è stato trovata in quantità oltre la soglia nella città di Palermo ed esattamente a Villa Niscemi e all’hotel Politeama. In queste strutture occorreranno precisi interventi. Sono in corso diversi controlli in diverse altre strutture alberghiere e pubbliche.
I tecnici al lavoro anche oggi
“Oggi, giovedì 15 settembre, i tecnici effettuano controlli e campionature anche in via Principe di Belmonte dove si sospetta la presenza del batterio in alcuni edifici” concludono dall’Asp il cui compito è quello di verificare non soltanto se il batterio è presente davvero in limiti superiori a quelli consentiti ma anche accertare se si trovi nelle tubature pubbliche o negli impianti interni. Quest’ultima eventualità è quella che è stata, fino ad ora, riscontrato negli altri siti casi

Commenta con Facebook